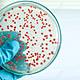
51329778 prueba de laboratorio de microbiología

-
El cientifico Robert Hooke diseño el primer microscopio compuesto, en el cual se utilizaban dos sistemas de lentes, las lentes oculares. Publicó Micrographia, el primer libro en el que se describían las observaciones de varios organismos realizadas a través de su microscopio. En su libro, Robert Hooke llamó a los numerosos compartimientos divididos por paredes “células”. El descubrimiento de las células a su vez provocó el rápido avance del microscopio.
-
Observo mediante un microscopio fabricado por el que en una gota de agua vivian cientos de diminutos animales a los que el llamaria animaculos. Fue muy probablemente el primero en observar microorganismos al microscopio.
-
Demostró que los microorganismos producían la alteración de alimentos y descubrió la pasteurización que consiste en aplicarle a un liquido durante un periodo de 30 minutos una temperatura de 65 grados
-
Descubrió la teoría infecciosa de las enfermedades, es decir, se demostró que las enfermedades están producidas por microorganismos este descubrimiento.
-
El alemán Kock descubrió que una bacteria causaba una cierta enfermedad e ideo los medios de cultivo. Descubrió el agente causante de la tuberculosis.
-
Descubrió el fundamento de las vacunas mediante la inyección de bacterias viejas, las cuales, habían perdido la capacidad de producir la enfermedad pero en cambio inducían a la inmunidad frente a los ataques de bacterias jóvenes.
-
Nace la quimioterapia, esta técnica consistía en la busca de sustancias químicas para destruir a diversos microorganismos.
-
Descubrió el Salvansaw efectivo contra la sífilis.
-
Descubre la penicilina, este descubrimiento fue casual.
-
Descubren las sulfamidas.
-
Consiguen sintetizar la penicilina en forma cristalina.
-
1944 McLead, McCartry y Awery descubren que el ADN es el material genético de las bacterias.
-
Descubren la estructura del ADN y como se replica. Estos dos hechos abrieron el camino de la denominación de ADN recombinante, que es la unión de fragmentos de ADN (genes) de origen vegetal o animal que son unidos a otros genes bacterianos, entonces el ADN recibe el nombre de ADNhibrido. El cual se le introduce a la bacteria y esta lo toma como propio y empieza a sintetizar las proteínas ordenadas.
-
Descubre el interferol que puede inhibir la replicación de algunos virus el interferol esta en nuestro propio organismo.-En esta época nace la virología que es la ciencia dedicada al estudio de los virus. El primer virus fue descubierto por Dimitri Iwanoski y fue el del polio del tabaco.
-
Marshall Nirenberg y H. Gobind Khorana terminaron el pilar del descubrimiento del código genético lo cual fue un gran logro para microbiologia y la bioquímica moderna, usaron mensajeros secuenciados y lograron deducir que eran necesarios tres bases para codificar un aminoácido y entre mas bases mas bases se lograban codificar mas aminoácidos.
-
A finales de la decada del setenta Thomas Brock con ayuda de otros colaboradores encontraron en el parque yellowstone entre fracturas del piso oceanico, la bacteria sulfolobus del filum archaeafue una una de las primeras en descubrirse, lo cual significo un logro para la biologia y otras ciencias naturales.
-
Tras el descubrimiento de la enzima transcriptasa inversa por Howard Temin se pudo ahondar en investigaciones exahustivas asi como en sus mecanismos de acción y su manipulación experimental, pues en 1911 se había descubierto el primer retrovirus pero sin poder ahondar en una información muy útil.
-
Georges Koholer y Cesar Milstein fusionaron por primera vez linfocitos con células de un mieloma y obtuvieron un hibridoma: una línea celular inmortal capaz de producir anticuerpos específicos o monoclonales.
-
arl Stetter logro aislar el primer organismo vivo procariote con una temperatura optima mayor a 100°C.
-
Jean Luc Montagnier hizo un gran a la microbiologia y otras ciencias, descubrió el Virus de Inmunodeficiencia Humana (VIH) vinculado al sida, logro aislar el virus en un momento en que la población mundial estaba alarmada por su virulenta propagación y del cual se desconocían las causas.
-
Craig Venter ofrece un método de secuenciación más rápido y, junto a Hamilton O. Smith, trazan el genoma de la bacteria 'Haemophilus influenzae. La secuencian del genoma ha sido uno de los proyectos mas ambiciosos del hombre en el mundo de la ciencia.
-
H5N1 es una cepa altamente patógena de gripe aviar. La primera aparición de este tipo de gripe en humanos se dio en 1997 en Hong Kong.1 La infección en humanos coincidió con una epidemia de gripe aviaria, causada por la misma cepa, en la población de pollos en Hong Kong. El nombre H5N1 se refiere al tipo de los antígenos de superficie presentes en el virus: hemaglutinina tipo 5 y neuraminidasa tipo 1.
-
El influenzavirus A subtipo H1N1, mejor conocido como gripe A H1N1 humana o indistintamente A N1H1 humana , es un subtipo de influenzavirus tipo A del virus de la gripe, perteneciente a la familia de los Orthomyxoviridae.
El H1N1 ha mutado en diversos subtipos que incluyen la gripe española (extinta en la vida silvestre), la gripe porcina, la gripe aviar y la gripe bovina. La cepa mantiene su circulación después de haber sido re introducida por la población humana en los años 1970.
Looking for a timeline maker?
Create timelines for projects, roadmaps, history, lessons, legal cases, and stories with Timetoast. Timetoast is a timeline maker for work, school, research, and stories.